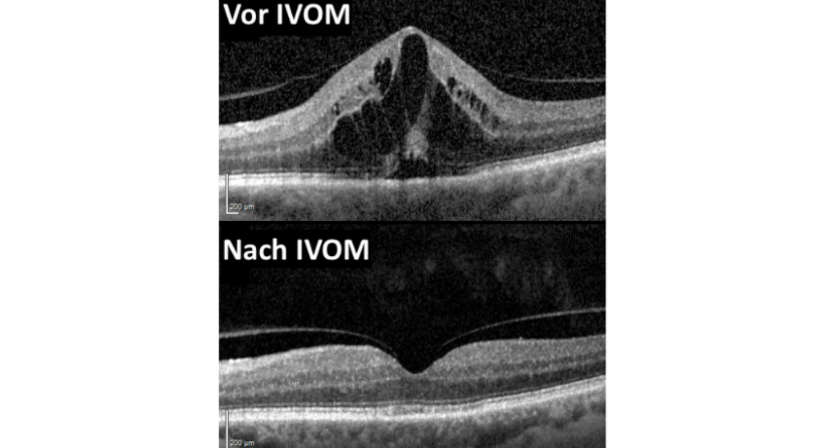
IVOM (Intravitreale Medikamenteneingabe) - Prof. Dr. Martin Dirisamer, FEBO - Augenarzt Linz 4020

Weitere Ärzte werden angezeigt
Ärzte im Umkreis oder aus dem Netzwerk des Arztes/der Ärztin
In Ergänzung zum ausgewählten Arztprofil werden PatientInnen auch weitere Arztprofile vorgestellt, um sie bei der Suche nach dem passenden Arzt/der passenden Ärztin für ihr gesundheitliches Anliegen zu unterstützen. Standardmäßig werden Ärzte abgebildet, die sich im Umkreis befinden und auch von anderen PatientInnen empfohlen wurden. In Abstimmung des jeweiligen Arzt/der jeweiligen Ärztin mit DocFinder können auch KollegInnen aus dem Netzwerk des Arztes/der Ärztin unentgeltlich dargestellt
werden, mit denen dieser/diese zusammenarbeitet bzw. an sie verweist. Bei Ärzten mit Portraitbild handelt es sich um kostenpflichtige Premium-Einträge, die erweiterte Informationen bieten.
Erklärung zum Bewertungssystem
Bewertungsskala
Bewertungen auf DocFinder werden mit dem DocFinder-Logo durchgeführt. Je mehr DocFinder-Symbole/Punkte ein Arzt/eine Ärztin erhält, desto besser wurde er/sie bewertet.
Die Bewertungsskala orientiert sich an international gängigen Standards:
- 1 Punkt (geringste Punktezahl = geringste Zufriedenheit)
- 2 Punkte
- 3 Punkte
- 4 Punkte
- 5 Punkte (höchste Punktezahl = höchste Zufriedenheit)
Umstellung der Bewertungsskala
Bis Ende September 2018 hat sich die Bewertungsskala an das österreichische Schulnotensystem angelehnt. Bewertungen, die bis zu diesem Zeitpunkt auf DocFinder abgegeben wurden, wurden wie folgt aliquot in die neue Bewertungsskala überführt, weshalb es auch einzelne Bewertungen mit Kommazahlen gibt.
Umrechnung alte auf neue Bewertungsskala:
- 0 Punkte (nicht genügend) → neue Skala: 1 Punkt
- 1 Punkt (genügend) → neue Skala: 1,8 Punkte
- 2 Punkte (befriedigend) → neue Skala: 2,6 Punkte
- 3 Punkte (gut) → neue Skala: 3,4 Punkte
- 4 Punkte (sehr gut) → neue Skala: 4,2 Punkte
- 5 Punkte (ausgezeichnet) → neue Skala: 5 Punkte
Bewertungsfragen
Anbei finden Sie Erklärungen zu unseren Fragen, die Ihnen bei Ihrer Bewertung helfen können. Bitte berücksichtigen Sie, dass diese Fragen Ihre persönliche, subjektive Meinung abfragen und widerspiegeln.
1. Gesamtbewertung
- Wie gut haben Sie sich bei diesem Arzt aufgehoben gefühlt?
- Wie sehr würden Sie diesen Arzt anderen Patienten weiterempfehlen?
2. Einfühlungsvermögen des Arztes
- Hatten Sie das Gefühl, dass der Arzt auf Ihre Bedürfnisse eingegangen ist?
- Hat er sich Zeit genommen und sich mit Ihrem Anliegen auseinandergesetzt?
- Wie einfühlsam haben Sie den Arzt empfunden?
3. Vertrauen zum Arzt
- Wie sieht Ihr Vertrauensverhältnis zu diesem Arzt aus?
- Haben Sie eine offene Gesprächsbasis mit ihm?
- Fühlen Sie sich wohl aufgehoben und haben Sie das Gefühl, dass der Arzt weiß was er tut?
- Haben Sie das Gefühl, dass er Ihre Interessen wahr nimmt und sich für Sie einsetzt?
4. Zufriedenheit mit Behandlung
- Wie zufrieden waren Sie in Ihrem Fall mit der ärztlichen Beratung/Behandlung?
- Hat der Arzt Ihre Erwartungen erfüllt?
5. Serviceangebot
- Was halten Sie von dem Serviceangebot des Arztes?
- Deckt es Ihre Bedürfnisse ab bzw. wäre eine Ausweitung des Angebotes wünschenswert?
6. Praxisausstattung/Räumlichkeiten
- Ist die Praxis (Warteraum, Behandlungsraum, Sanitäranlagen wie WC und/oder Bad) angemessen für den Arztbesuch ausgestattet?
- Sind die Räumlichkeiten sauber?
- Sind die Instrumente/Geräte ausreichend für eine Diagnose bzw. Behandlung und können die gängigsten Behandlungen direkt vor Ort durchgeführt werden?
7. Betreuung durch Arzthelfer(innen)
- Wie haben Sie die Betreuung durch die Arzthelfer/innen empfunden?
- Sind die Mitarbeiter auf Ihre Anliegen eingegangen?
- Waren Sie freundlich?
- Sofern es keine Arzthelfer(innen) gibt: Bitte bewerten Sie ob Sie damit zufrieden waren oder ob eine Betreuung durch Arzthelfer(innen) wünschenswert gewesen wäre?
8. Terminvereinbarung
Benötigten Sie für Ihren Arztbesuch eine Terminvereinbarung?
9. Zufriedenheit Wartezeit auf Termin
- Wie sehr hat die Wartezeit auf Ihren Arzttermin Ihren Erwartungen entsprochen?
- Beispiel: Sie wissen, dass man zumeist 3 Tage auf einen Termin bei diesem Arzt warten muss und bekommen Ihren Termin in 3 Tagen. Also hat die Wartezeit Ihren Erwartungen sehr gut entsprochen.
10. Zufriedenheit Wartezeit im Warteraum
- Wie sehr hat die Wartezeit im Warteraum Ihren Erwartungen entsprochen?
- Beispiel: Sie wissen bereits, dass Sie wahrscheinlich 2 Stunden warten müssen und warten in Wirklichkeit 1:50 Stunde. Also hat die Wartezeit Ihren Erwartungen sehr gut entsprochen.